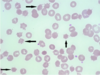

Qu’est-ce qu’un syndrome glomérulaire et quand l’évoquer ?
Un syndrome glomérulaire correspond à l’association de signes biologiques et cliniques qui traduisent une atteinte des glomérules rénaux, c’est-à-dire l’unité de filtration du rein.
En pratique, c’est un mot-clé qui désigne un ensemble d’anomalies orientant vers une glomérulopathie.
Une pathologie glomérulaire est évoquée devant un ou les deux signes suivants :
- une protéinurie glomérulaire
- hématurie glomérulaire
- Trois autres signes peuvent être associés : HTA, oedèmes, insuffisance rénale aigue ou chronique
Quels sont les syndromes glomérulaires à connaître ?
- syndrome d’hématurie macroscopique récidivante.
- syndrome de glomérulonéphrite chronique.
- syndrome néphrotique.
- syndrome néphritique aigu.
- syndrome de glomérulonéphrite rapidement progressive.
donner le tableau récap des différents types de syndrome glomérulaire avec
- les signes
- la ou les atteintes rénales correspondantes au syndrome
- les particularités du syndrome

Quelles sont les principales entités pathologiques pouvant se compliquer de néphropathies glomérulaires ?
- infections bactériennes (aigues ou chroniques)
- infections virales : VIH VHB VHC
- maladies métaboliques : diabète
- maladies systémiques : vascularites, lupus, maladies inflammatoires chroniques (PR, SpA, MICI)
- gammapathies monoclonales : myélome, gammapathie monoclonale à signification rénale (MGRS)
- maladies génétiques
compléter le tableau suivant : il s’agit pour chaque entité responsable de néphropathie glomérulaire de dire quelle néphropathie glomérulaire ça donne
(la colonne du milieu OSEF)

pour VIH ajouter hyalinose segmentaire et focale
pour infection bactérienne aigue ajouter GNRP

Devant un syndrome de néphropathie glomérulaire, il y a indication à discuter d’une biopsie à l’exception de :
Biopsie rénale encadrée par un néphrologue si néphropathie glomérulaire à l’exception des cas suivants où la PBR n’est pas réalisée systématiquement :
- syndrome néphrotique pur chez un enfant âgé de 1 à 10 ans.
- syndrome néphrotique avec recherche positive d’Ac anti-PLA2R (GEM : on peut porter le diagnostic de GEM sans PBR devant association sd nephrotique + Ac anti PLA2R)
- rétinopathie diabétique au fond d’oeil sans hématurie chez un patient ayant un diabète connu
- amylose documentée sur une biopsie non rénale (glandes salivaires)
- glomérulopathie héréditaire déjà documentée dans la famille.
Quelles sont les contre-indications à la PBR ?
- rein unique fonctionnel
- HTA mal contrôlée (CI jusqu’au contrôle de l’HTA)
- anomalies anatomiques (kystes multiples, rein en fer à cheval, suspicion de périartérite noueuse…)
- pyélonéphrite aigue (CI relative et temporaire)
- troubles de la coag/hémostase (arrêt des antiagregants plaquettaires 5 jours avant, du clopidogrel 10 jours avant).
décrire et faire un schéma de l’histologie du glomérule normal
La structure est la suivante :
Il existe trois types de cellules glomérulaires :
1- Les cellules épithéliales :
- c épithéliales pariétales, tapissant la capsule de Bowman
- c épithéliales viscérales = podocytes : en contact avec le versant externe de la MBG par l’intermédiaire d’extensions cellulaires appelées pédicelles
2- Les cellules endothéliales, fenestrées et constituant la paroi du capillaire glomérulaire. Elles reposent sur le versant interne de la MBG
3- Les cellules mésangiales, présentes dans le mésangium qui est un tissu de soutien. Elles élaborent de nombreuses protéines de la matrice extracellulaire et sont capables de se contracter, modulant ainsi la surface de filtration glomérulaire
La membrane basale glomérulaire à l’interface des cellules endothéliales et des podocytes
La barrière de filtration est donc constituée :
- sur son versant interne par la cellule endothéliale
- par la membrane basale glomérulaire
- et sur le versant externe par le podocyte et ses pédicelles reliés les uns aux autres par les diaphragmes de fentes

A propos des lésions glomérulaires élémentaires : quelles sont schématiquement les 4 types de lésions glomérulaires élémentaires que l’on peut retrouver dans les glomérulopathies ?
- la prolifération cellulaire (tous les types cellulaires peuvent être concernés)
- la sclérose (ou fibrose), accumulation cicatricielle d’un matériel de nature collagénique
- les dépôts de chaîne d’immunoglobuline, ou de complément
- autres dépôts : Hyalins (HSF), amyloides (chaînes d’Ig : amylose AL, Sérum amyloide A : amylose AA), de protéines et de matrice extracellulaire glycosylées (diabète)
à propos des dépôts glomérulaires, donner la localisation glomérulaire des dépôts en fonction de la dénomination de ceux-ci

compléter le tableau suivant


Dans quelles circonstances est-il possible de poser le diagnostic de GEM sans biopsie rénale ?
Devant l’association syndrome néphrotique et anticorps sérique anti-PLA2R (anti-récepteur de la phospholipase A2, antigène podocytaire)
Qu’est-ce qu’on retrouve histologiquement dans une GEM ?
A la PBR :
en microscopie optique :
- une absence de prolifération cellulaire
- une MBG normale ou épaissie et spiculée sur son versant externe
en immunofluorescence :
- dépôts extra-membraneux granuleux constitués d’IgG et de C3.
La GEM peut être primitive dans …% des cas ou secondaire dans …% des cas. Quelles sont les causes de GEM secondaires ?
primitives dans 85% des cas
secondaires dans 15% des cas

Pronostic des GEM primitives
- 25% des cas : rémission spontanée
- 50% des cas : rémission partielle avec persistance d’une protéinurie
- 25% des cas : insuffisance rénale chronique lentement progressive
quelles sont les complications des GEM ?
- ce sont les complications liées au syndrome néphrotique (cf chapitre approprié) mais surtout c’est la thrombose des veines rénales, qui est une complication assez spécifique de la GEM
Quelle différence entre albuminurie A2 et albuminurie A3 ?
Albuminurie A2, anciennement microalbuminurie –> Albuminurie/créatininurie>=30mg/g ([A/C]>=30 mg/g)
Albuminurie A3 –> protéinurie détéctable à la BU : albuminurie >= 300 mg/24h ou >300mg/g créatininurie
donner les signes néphrologiques et leur ordre d’apparition dans le diabète de type 1 et de type 2
Dans le diabète de type 1 : succession albuminurie A2, albuminurie A3 (syndrome néphrotique dans 10 % des cas) et HTA, puis insuffisance rénale. Absence habituelle d’hématurie. Reins de taille normale lors de l’IRC terminale.
Dans le diabète de type 2 : idem sauf que l’HTA précède la néphropathie et les signes néphrologiques peuvent être présents à la découverte du diabète. Dans 25 % des cas, l’insuffisance rénale chronique n’est pas associée à une albuminurie.
Histologie de la néphropathie diabétique dans le DT1
L’atteinte rénale du diabète de type 1 est presque toujours une glomérulosclérose diabétique.
Description de la glomérulosclérose diabétique (figure 2) :
- Stade 1 : épaississement des membranes basales glomérulaires visible en ME.
- Stade 2 : expansion mésangiale.
- Stade 3 : poursuite de l’expansion mésangiale et constitution de nodules extracellulaire dits de Kimmelstiel-Wilson dans au moins un glomérule.
- Stade 4 : glomérulosclérose globale (> 50 % glomérules).

Histologie de la néphropathie diabétique dans le DT2
L’atteinte rénale du diabète de type 2 est beaucoup plus hétérogène :
- 1/3 seulement des patients développent isolément des lésions caractéristiques de glomérulosclérose diabétique ;
- 1/3 des patients ont des lésions vasculaires prédominantes de type endartérite fibreuse (néphroangiosclérose) ;
- 1/3 n’a pas d’atteinte diabétique mais une néphropathie d’autre nature ou surajoutée aux lésions du diabète justifiant la réalisation d’une biopsie rénale.
indication des IEC chez le sujet diabétique
Chez les diabétiques de type 1 ou 2 les IEC sont indiqués dès que l’albuminurie est >=30 mg/g de créatininurie (A2 ou A3)
Ils ralentissent la progression de la néphropathie
Si intolérence aux IEC –> ARA2
néphropathie diabétique :
- quelle place pour les iSGLT2 ?
- les agonistes GLP1 ?
- la finérénone ?
- apports protéiques ?
- pec des fdr CV ?
- Les iSGLT2 sont recommandés en première intention dans le DT2 en association à la metformine en cas de MRC associée au diabète. L’effet nephroprotecteur est additif à celui des bloqueurs du SRAA
- les agonistes du GLP1 ont aussi montré leur effet cardioprotecteur et néphroprotecteur chez les patients diabétiques
- la finérénone est un antagoniste non stéroidien du récepteur minéralocorticoide pas encore commercialisé en France. Il a un effet néphroprotecteur au cours de la néphropathie diabétique.
- un excès de protéines alimentaires a un effet délétère sur l’évolution de la fonction rénale. Chez le diabétique avec néphropathie, un *apport d’environ 0,6 à 0,8 g prot/kg/j est recommandé lorsque le DFG <60 mL/min
- prise en charge des autres fdr CV : statines, kardegic, tabac
Néphropathie diabétique, dans quels cas l’intervention du néphrologue est-elle nécessaire ?
- doute diagnostique
- albuminurie >300mg/j ou 300mg/g de créat malgré ttt symptomatique
- en cas d’HTA non contrôlée (suspicion sténose artère rénale)
- déclin rapide du DFG >5ml/min/an
- DFG <45 ml/min
Quelle est en France la cible tensionnelle recommandée chez le diabétique avec signes de néphropathies ?
<= 130/80
à noter que toutes les reco internationales ne sont pas concordantes, pour la France on retiendra cela